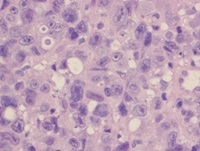

- Home
- Diergezondheid
- Dierziekten
- Prostaataandoeningen
Prostaataandoeningen
Bij reuen vanaf ongeveer 5 jaar zijn prostaatproblemen niet zeldzaam. Prostaataandoeningen resulteren bijna altijd in een prostaatvergroting, waardoor de klinische verschijnselen grotendeels overeenkomen. Vóór het instellen van de behandeling is het daarom belangrijk om eerst een juiste diagnose te stellen.
Dierziekte informatie Prostaataandoeningen
De prostaat, bestaande uit musculoglandulair weefsel, is de belangrijkste accessoire geslachtsklier bij de reu en omvat bijna de gehele proximale urethra. De secretoire functie van de prostaat staat onder invloed van androgenen en de prostaat is verantwoordelijk voor 90-95% van de ejaculatievloeistof. Daarnaast bevat prostaatvloeistof een antibacteriële component, die het zaad beschermt en de incidentie van genitale infecties bij teven reduceert. De meest voorkomende aandoeningen van de prostaat zijn: benigne prostaat hyperplasie (BPH), prostatitis, squameuze metaplasie, prostaatcysten en maligne neoplasieën.
Benigne prostaathyperplasie
Benigne prostaathyperplasie (BPH) is de meest voorkomende aandoening van de prostaat en komt voor bij meer dan 80% van de intacte reuen ouder dan 5 jaar. De etiologie is nog onduidelijk. Naast androgene stimulatie spelen dihydrotestosteron (product van testiculair testosteron) en oestradiol een rol in de pathofysiologie van BPH. Een chronische ontsteking kan een aanvullende rol spelen in de progressie van de aandoening. De klinische verschijnselen van BPH kunnen bestaan uit constipatie, hematurie, bloedverlies na de mictie en lage rugpijn. Bij de meeste honden verloopt de aandoening subklinisch. De prostaat is symmetrisch vergroot en kan eventueel cysten bevatten.
Prostatitis
Ook prostatitis komt veel voor bij oudere honden. De aandoening wordt vaak geassocieerd met een bacteriële infectie van de prostaat, maar prostatitis kan ook voorkomen als gevolg van BPH. Een infectie kan ascenderend (vanuit de urethra) of descenderend (de hematogene route) ontstaan. Bij prostatitis kunnen de klachten ernstiger zijn dan bij BPH: pijn, dysurie, tenesmus, hematurie, pyurie en koorts. In de acute glandulaire fase, die vaak gepaard gaat met systemische verschijnselen, kunnen abcessen in het parenchym ontstaan die bij doorbraak een peritonitis en/of sepsis kunnen veroorzaken. Er bestaat ook een chronische interstitiële fase, welke zonder klinische symptomen aanwezig kan zijn.

Squameuze metaplasie
Als gevolg van een excessieve oestrogeenstimulatie kan er een squameuze metaplasie van de epitheelcellen in de prostaat optreden. Een excessieve oestrogeenstimulatie kan veroorzaakt worden door exogene oestrogeentoediening of door endogene oestrogenen die geproduceerd worden door een sertolicel-tumor. Squameuze metaplasie kan leiden tot een obstructie van de ductus en vorming van cysten of abcessen. Oestrogenen kunnen prostaatatrofie geven, alhoewel na chronische blootstelling ook een milde prostaatvergroting kan optreden. Secundaire vorming van cysten en abcessen kan dan voor een verdere vergroting zorgen. Daarnaast kunnen andere verschijnselen van hyperoestrogenisme voorkomen zoals alopecia, hyperpigmentatie en gynaecomastie.
Prostaatcysten
Prostaatcysten komen met name voor bij honden waarbij BPH of een andere prostaataandoening aanwezig is. Een cysteuze prostaat kan asymmetrisch vergroot zijn. Parenchymateuze cysten ontwikkelen zich in het parenchym en zijn omkapseld met centrale holtevorming. De holtes bevatten heldere of troebele vloeistof. Paraprostaatcysten bevinden zich aan de buitenzijde van de prostaat en breiden zich uit in de ruimte tussen de prostaat en de urineblaas. Ze kunnen vrij groot worden, waardoor er compressie kan optreden van het colon descendens, het rectum en andere structuren in het bekken. Dit kan zelfs leiden tot een hernia perinealis. Paraprostaatcysten kunnen mineraliseren, waardoor er metaplastische (kraak) beenvorming kan optreden (zie foto).

Maligne neoplasieën
Maligne neoplasieën omvatten ongeveer 5% van de prostaataandoeningen, waarbij een adenocarcinoom van de prostaat het meest voorkomt. De aandoening komt met name voor bij oudere honden (gemiddeld 8 - 10 jaar), waarbij de incidentie bij gecastreerde reuen hoger is dan bij intacte reuen. Het carcinoom ontwikkelt zich bij de hond vaak op de plaats waar de urethra de prostaat passeert. Adenocarcinomen van de prostaat zijn vaak asymmetrisch en zeer sterk vergroot en kunnen op abdominale organen drukken waardoor dysurie en tenesmus kunnen ontstaan. Andere klinische verschijnselen zijn hematurie, anorexie en vermageren. Sommige honden vertonen klachten van myelopathie of kreupelheid als gevolg van metastasering naar het bekken en/of de lumbale wervelkolom. Neoplastische cellen kunnen cytologisch zichtbaar zijn in urine of prostaatvloeistof. Andere neoplasieën die voor kunnen komen in de prostaat zijn: overgangsepitheel carcinoom, leiomyosarcoom en haemangiosarcoom.
Cytologie of histologie
Cytologisch beeld van BPH van een zuigbiopt (links) en een percutaan biopt